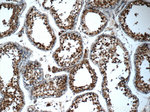
SMC4 Antibody in Immunohistochemistry (Paraffin) (IHC (P))

Search
Proteintech
SMC4 Polyclonal Antibody
{{$productOrderCtrl.translations['antibody.pdp.commerceCard.promotion.promotions']}}
{{$productOrderCtrl.translations['antibody.pdp.commerceCard.promotion.viewpromo']}}
{{$productOrderCtrl.translations['antibody.pdp.commerceCard.promotion.promocode']}}: {{promo.promoCode}} {{promo.promoTitle}} {{promo.promoDescription}}. {{$productOrderCtrl.translations['antibody.pdp.commerceCard.promotion.learnmore']}}
产品信息
24758-1-AP
种属反应
已发表种属
宿主/亚型
分类
类型
抗原
偶联物
形式
浓度
规格
纯化类型
保存液
内含物
保存条件
运输条件
产品详细信息
Immunogen sequence: SVLIHNSDE HKDIQSCTVE VHFQKIIDKE GDDYEVIPNS NFYVSRTACR DNTSVYHISG KKKTFKDVGN LLRSHGIDLD HNRFLILQGE VEQIAMMKPK GQTEHDEGML EYLEDIIGCG RLNEPIKVLC RRVEILNEHR GEKLNRVKMV EKEKDALEGE KNIAIEFLTL ENEIFRKKNH VCQYYIYELQ KRIAEMETQK EKIHEDTKEI NEKSNILSNE MKAKNKDVKD TEKKLNKITK FIEENKEKFT QLDLEDVQVR EKLKHATSKA KKLEKQLQKD KEKVEEFKSI PAKSNNII (992-1288 aa encoded by BC106033)
靶标信息
The proteins belonging to structural maintenance of chromosomes (SMC) family play critical roles in chromosome structural changes. SMC proteins are involved in the proper condensation and segregation of mitotic chromosomes. Four human SMC proteins that form two distinct heterodimeric complexes in the cell, the human chromosome-associated protein (hCAP)-C and hCAP-E protein complex (hCAP-C/hCAP-E), and the human SMC1 (hSMC1) and hSMC3 protein complex (hSMC1/hSMC3) have been identified.
仅用于科研。不用于诊断过程。未经明确授权不得转售。
生物信息学
蛋白别名: Chromosome-associated polypeptide C; hCAP-C; SMC protein 4; SMC4 structural maintenance of chromosomes 4-like 1; structural maintenance of chromosomes (SMC) family member; Structural maintenance of chromosomes protein 4; unnamed protein product; XCAP-C homolog
基因别名: CAP-C; CAPC; SMC-4; SMC4; SMC4L1
UniProt ID: (Human) Q9NTJ3
Entrez Gene ID: (Human) 10051